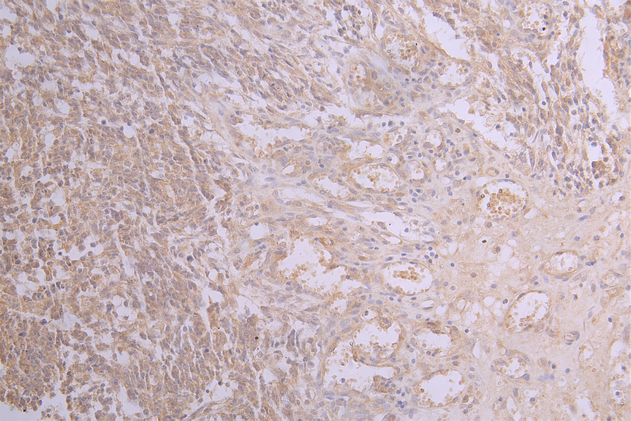

-
中文名稱:APP重組抗體
-
貨號:CSB-RA001950MA2HU
-
規格:¥1320
-
圖片:
-
IHC image of CSB-RA001950MA2HU diluted at 1:50 and staining in paraffin-embedded human testis tissue performed on a Leica BondTM system. After dewaxing and hydration, antigen retrieval was mediated by high pressure in a citrate buffer (pH 6.0). Section was blocked with 10% normal goat serum 30min at RT. Then primary antibody (1% BSA) was incubated at 4°C overnight. The primary is detected by a Goat anti-human polymer IgG labeled by HRP and visualized using 0.05% DAB.
-
IHC image of CSB-RA001950MA2HU diluted at 1:50 and staining in paraffin-embedded human brain tissue performed on a Leica BondTM system. After dewaxing and hydration, antigen retrieval was mediated by high pressure in a citrate buffer (pH 6.0). Section was blocked with 10% normal goat serum 30min at RT. Then primary antibody (1% BSA) was incubated at 4°C overnight. The primary is detected by a Goat anti-human polymer IgG labeled by HRP and visualized using 0.05% DAB.
-
IHC image of CSB-RA001950MA2HU diluted at 1:50 and staining in paraffin-embedded human glioma cancer performed on a Leica BondTM system. After dewaxing and hydration, antigen retrieval was mediated by high pressure in a citrate buffer (pH 6.0). Section was blocked with 10% normal goat serum 30min at RT. Then primary antibody (1% BSA) was incubated at 4°C overnight. The primary is detected by a Goat anti-human polymer IgG labeled by HRP and visualized using 0.05% DAB.
-
Immunofluorescence staining of SH-SY5Y cell with CSB-RA001950MA2HU at 1:20, counter-stained with DAPI. The cells were fixed in 4% formaldehyde and blocked in 10% normal Goat Serum. The cells were then incubated with the antibody overnight at 4C. The secondary antibody was FITC-conjugated AffiniPure Goat Anti-Human IgG(H+L).
-
-
其他:
產品詳情
-
產品描述:CSB-RA001950MA2HU APP重組單克隆抗體是針對淀粉樣前體蛋白(Amyloid Precursor Protein, APP)設計的高特異性科研工具。APP是一種跨膜糖蛋白,在神經細胞黏附、軸突生長及突觸可塑性中發揮重要作用,其異常代謝產物β-淀粉樣蛋白(Aβ)的積累與阿爾茨海默病等神經退行性病變密切相關。本抗體采用重組表達技術制備,經ELISA、免疫組化(IHC)和免疫熒光(IF)嚴格驗證,在推薦稀釋度(IHC 1:50-1:200,IF 1:50-1:200)下可清晰檢測內源性APP蛋白在多種樣本中的表達與分布,實驗數據顯示批次間穩定性和抗原結合一致性優異。適用于體外培養細胞、動物腦組織切片等樣本的蛋白定位研究,可助力阿爾茨海默病機制探索、APP代謝通路分析及神經退行性疾病相關藥物開發等基礎研究領域,為神經科學領域的蛋白功能研究提供可靠檢測方案。
-
Uniprot No.:
-
基因名:
-
別名:A4 antibody; A4_HUMAN antibody; AAA antibody; ABETA antibody; ABPP antibody; AICD-50 antibody; AICD-57 antibody; AICD-59 antibody; AID(50) antibody; AID(57) antibody; AID(59) antibody; Alzheimer disease amyloid protein antibody; Amyloid intracellular domain 50 antibody; Amyloid intracellular domain 57 antibody; Amyloid intracellular domain 59 antibody; APP antibody; APPI antibody; Beta amyloid protein 42 antibody; Beta APP42 antibody; Beta-APP40 antibody; Beta-APP42 antibody; C31 antibody; Cerebral vascular amyloid peptide antibody; CVAP antibody; Gamma-CTF(50) antibody; Gamma-CTF(57) antibody; Gamma-CTF(59) antibody; PN-II antibody; PreA4 antibody; Protease nexin-II antibody; S-APP-alpha antibody; S-APP-beta antibody
-
反應種屬:Human
-
免疫原:Recombinant Human APP protein
-
免疫原種屬:Homo sapiens (Human)
-
標記方式:Non-conjugated
-
克隆類型:Monoclonal
-
抗體亞型:hIgG1
-
純化方式:Affinity-chromatography
-
克隆號:5H10
-
濃度:It differs from different batches. Please contact us to confirm it.
-
保存緩沖液:Preservative: 0.03% Proclin 300
Constituents: 50% Glycerol, 0.01M PBS, PH 7.4 -
產品提供形式:Liquid
-
應用范圍:ELISA, IHC, IF
-
推薦稀釋比:
Application Recommended Dilution IHC 1:50-1:200 IF 1:50-1:200 -
Protocols:
-
儲存條件:Upon receipt, store at -20°C or -80°C. Avoid repeated freeze.
-
貨期:Basically, we can dispatch the products out in 1-3 working days after receiving your orders. Delivery time maybe differs from different purchasing way or location, please kindly consult your local distributors for specific delivery time.
-
用途:For Research Use Only. Not for use in diagnostic or therapeutic procedures.
相關產品
靶點詳情
-
功能:Functions as a cell surface receptor and performs physiological functions on the surface of neurons relevant to neurite growth, neuronal adhesion and axonogenesis. Interaction between APP molecules on neighboring cells promotes synaptogenesis. Involved in cell mobility and transcription regulation through protein-protein interactions. Can promote transcription activation through binding to APBB1-KAT5 and inhibits Notch signaling through interaction with Numb. Couples to apoptosis-inducing pathways such as those mediated by G(O) and JIP. Inhibits G(o) alpha ATPase activity. Acts as a kinesin I membrane receptor, mediating the axonal transport of beta-secretase and presenilin 1. By acting as a kinesin I membrane receptor, plays a role in axonal anterograde transport of cargo towards synapes in axons. Involved in copper homeostasis/oxidative stress through copper ion reduction. In vitro, copper-metallated APP induces neuronal death directly or is potentiated through Cu(2+)-mediated low-density lipoprotein oxidation. Can regulate neurite outgrowth through binding to components of the extracellular matrix such as heparin and collagen I and IV. The splice isoforms that contain the BPTI domain possess protease inhibitor activity. Induces a AGER-dependent pathway that involves activation of p38 MAPK, resulting in internalization of amyloid-beta peptide and leading to mitochondrial dysfunction in cultured cortical neurons. Provides Cu(2+) ions for GPC1 which are required for release of nitric oxide (NO) and subsequent degradation of the heparan sulfate chains on GPC1.; Amyloid-beta peptides are lipophilic metal chelators with metal-reducing activity. Bind transient metals such as copper, zinc and iron. In vitro, can reduce Cu(2+) and Fe(3+) to Cu(+) and Fe(2+), respectively. Amyloid-beta protein 42 is a more effective reductant than amyloid-beta protein 40. Amyloid-beta peptides bind to lipoproteins and apolipoproteins E and J in the CSF and to HDL particles in plasma, inhibiting metal-catalyzed oxidation of lipoproteins. APP42-beta may activate mononuclear phagocytes in the brain and elicit inflammatory responses. Promotes both tau aggregation and TPK II-mediated phosphorylation. Interaction with overexpressed HADH2 leads to oxidative stress and neurotoxicity. Also binds GPC1 in lipid rafts.; Appicans elicit adhesion of neural cells to the extracellular matrix and may regulate neurite outgrowth in the brain.; The gamma-CTF peptides as well as the caspase-cleaved peptides, including C31, are potent enhancers of neuronal apoptosis.; N-APP binds TNFRSF21 triggering caspase activation and degeneration of both neuronal cell bodies (via caspase-3) and axons (via caspase-6).
-
基因功能參考文獻:
- genetic manipulation of Sirt3 revealed that amyloid-beta increased levels of total tau acetylated tau through its modulation of Sirt3. PMID: 29574628
- brain. In the present study, two familial Ab42 mutations, namely A2V (harmful) and A2T (protective) have been analyzed and compared with the wild-type (WT) by performing all-atom molecular dynamics (MD) simulations in the absence and presence of curcumin, a well-known inhibitor of Abeta plaque formation. Mutant A2V was found to exhibit highest stability followed by WT and mutant A2T in the absence of curcumin PMID: 28054501
- These results provide evidence for an emerging role of BAG-1M in the regulation of BACE1 expression and AD pathogenesis and that targeting the BAG-1M-NF-kappaB complex may provide a mechanism for inhibiting Abeta production and plaque formation. PMID: 28502705
- A physical interaction between nicastrin (hNCT) and the gamma-secretase substrate amyloid beta-protein precursor (APPC100) confirmed the functionality of hNCT as a substrate recognizer. PMID: 28276527
- ethanol-induced eIF2alpha phosphorylation stimulates COX-2 expression and PGE2 production which induces the BACE1 expression and Abeta production via EP-2 receptor-dependent PKA/CREB pathway. PMID: 28668332
- Western diet (WD) dramatically increases ABETA levels and generates pyroglutamate-ABETA deposits. PMID: 28039031
- This study demonstrated that the APP21 transgenic rats develop age-dependent cognitive impairment and accelerated white matter inflammation. PMID: 30153843
- Data suggest that kinetics of degradation/proteolysis versus of aggregation of amyloid beta(1-40) and amyloid beta(1-42) at specific concentrations of amyloid beta, cathepsin B, and cystatin C can be modeled and predicted. PMID: 29046353
- In vitro neuroprotective effects of naringenin nanoemulsion against beta-amyloid toxicity through the regulation of amyloidogenesis and tau phosphorylation. PMID: 30001606
- The results of study demonstrate that different degradation pathways play distinct roles in the removal of Abeta42 aggregates and in disease progression. These findings also suggest that pharmacologic treatments that are designed to stimulate cellular degradation pathways in patients with AD should be used with caution. PMID: 29127191
- This data demonstrates a specific function of APP or its metabolites is involved in the changes that occur during high fat diet-induced obesity. PMID: 28262782
- Our study provides new insights into the regulation of APP pre-mRNA processing, supports the role for nELAVLs as neuron-specific splicing regulators and reveals a novel function of AUF1 in alternative splicing. PMID: 28291226
- Data show that phospholipase D3 (PLD3) functions in endosomal protein sorting and plays an important role in regulating amyloid precursor protein (APP) processing. PMID: 29368044
- Data show that amyloid precursor protein (APP) dimerization affects its interaction with LDL receptor related protein 1 (LRP1) and LDL-receptor related protein SorLA (SorLA), suggesting that APP dimerization modulates its interplay with sorting molecules and in turn its localization and processing. PMID: 28799085
- overexpression of APP may promote the onset of seborrhoeic keratosis and is a marker of skin ageing and UV damage. PMID: 29487944
- Amyloid fibrils of Abeta1-40 peptide can effectively initiate amyloid formation in different globular proteins and metabolites, converting native structures into beta-sheet rich assemblies. Structural and biophysical properties of the resultant protein fibrils display amyloid like characteristic features. PMID: 29723530
- Structural and biochemical differences between the Notch and the amyloid precursor protein transmembrane domains. PMID: 28439555
- Gnetin C may thereby prevent Abeta toxicity by suppressing BACE1 and enhancing MMP-14, together with reducing both internalization and oligomerization of exogenous Abeta monomers. PMID: 29899186
- Amyloid precursor protein (APP) binds the HIV-1 Gag polyprotein, retains it in lipid rafts and blocks HIV-1 virion production and spread. PMID: 29142315
- ABETA(1-42) doses >5 microM inhibited the growth of U87 cells compared with the 0 microM group after 24 and 48 h treatment. PMID: 29568933
- On the role of sidechain size and charge in the aggregation of Abeta42 with familial mutations. PMID: 29895690
- The mechanism involved in the interaction of HSP60-Ass conjugate with HLA-DR-DRB allele considering the fact that Ass (1-42) is highly immunogenic in human and interactions evoked highly robust T-cell response through MHC class II binding predictions. PMID: 27106586
- Abeta fibrils start to accumulate predominantly within certain parts of the default mode network in preclinical Alzheimer's disease and already then affect brain connectivity. PMID: 29089479
- findings show adverse effects of one-night sleep deprivation on brain ABB and expand on prior findings of higher Abeta accumulation with chronic less sleep. PMID: 29632177
- This review highlights the existing link between oxidative stress and Alzheimer's disease, and the consequences towards the ABETA peptide and surrounding molecules in terms of oxidative damage. [review] PMID: 29080524
- This study presents nonequilibrium molecular dynamics data of the Amyloid beta (1-40) peptide, periodically driven by an oscillating electric field PMID: 29812922
- overall results and observations regarding human serum albumin, amyloid-beta, and metal ions advance our knowledge of how protein-protein interactions associated with amyloid-beta and metal ions could be linked to Alzheimer's disease pathogenesis PMID: 28930473
- electrostatic interactions in the center of the Abeta peptide sequence play a crucial role in the three-dimensional fold of the fibrils, and by inference, fibril-induced neuronal toxicity and AD pathogenesis PMID: 27414264
- This study applies methodologies on the initial stages of aggregation of a hexamer of Alzheimer's amyloid beta fragment 25-35 (ABETA 25-35) and finds that transitions within the hexameric aggregate are dominated by entropic barriers and speculates that especially the conformation entropy plays a major role in the formation of the fibril as a rate limiting factor. PMID: 29221375
- c-Abl is activated in AbetaOs exposed neurons and in Alzheimer's disease patient's brain, and the inhibition of activated c-Abl ameliorates cognitive deficits PMID: 29378302
- RelA, RelB and c-Rel can be activated by Abeta1-40, all of which mediate pro-inflammatory cytokine transcription and retinal pigment epithelium damage. PMID: 29022897
- specific balance between the concentrations of monomeric and fibrillar alpha-synuclein determines the outcome of the Abeta42 aggregation reaction PMID: 28698377
- Nuclear HSP70 leads to enhancement of vaccinia H1-related phosphatase (VHR) activity via protein-protein interaction rather than its molecular chaperone activity, thereby suppressing excessive ERK activation. Downregulation of either VRK3 or HSP70 rendered cells vulnerable to glutamate-induced apoptosis. PMID: 27941812
- The Network analyses identified APP expression in temporal cortex in patient with late-onset Alzheimer's disease. PMID: 28242297
- alpha-synuclein (Parkinson) and Abeta peptide (Alzheimer) no longer form Ca(2+)-permeable pores in presence of drugs that target either cholesterol or ganglioside or both membrane lipids. PMID: 27352802
- APP processing is regulated throughout differentiation of cortical neurons and that amyloidogenic APP processing, as reflected by Abeta1-40/42, is associated with mature neuronal phenotypes. PMID: 27383650
- Authors measured cerebral morphological and neurochemical alterations using structural magnetic resonance imaging (MRI) and proton magnetic resonance spectroscopy ((1)H-MRS) in an AD model of APP/PS1 transgenic mice. PMID: 28797599
- while Reelin expression is enhanced in the Alzheimer's brain, the interaction of Reelin with Abeta hinders its biological activity PMID: 27531658
- These results confirm the involvement of amyloid precursor protein (APP) in synaptogenesis and provide evidence to suggest that human APP overexpression specifically disturbs the structural and functional organization of active zone and results in altered Bruchpilot distribution and lowered probability of spontaneous neurotransmitter release. PMID: 28770114
- Enhancing mitochondrial proteostasis reduces amyloid-beta proteotoxicity PMID: 29211722
- Study showed that the APP Osaka mutation has dual effects: it causes a loss-of-function of APP and gain-of-toxic-function of Abeta, though the latter seems to come out only after the former causes GABAergic depletion. Also present OSK-KI mice as a mouse model to replicate the hereditary form of recessive familial Alzheimer's disease. PMID: 28760161
- results suggest that co-oligomers are a common form of aggregate when Abeta isoforms are present in solution and may potentially play a significant role in Alzheimer's disease. PMID: 27346247
- This study reports the transition dipole strengths and frequencies of the amyloid beta-sheet amide I mode for the aggregated proteins amyloid-beta1-40, calcitonin, alpha-synuclein, and glucagon. PMID: 28851219
- different Ramachandran angle values could possibly be traced to the unique conformational folding avenues sampled by the Abeta42 peptide owing to the presence of its two extra residues. PMID: 27808259
- This study structurally characterized ABETA 40 and ABETA 42 monomers through pentamers which were converted from previously derived coarse-grained (DMD4B-HYDRA) simulations into all-atom conformations and subjected to explicit-solvent Molecular Dynamics. PMID: 28727426
- Shape complementarity between close-packed residues plays a critical role in the amyloid aggregation process. This study probes such "steric zipper" interactions in amyloid-beta (ABETA 40), whose aggregation is linked to Alzheimer's disease, by replacing natural residues by their stereoisomers. Stereoisomers can cause complex site dependent changes in amyloid properties. PMID: 28140589
- Besides, the promoting effect of Zn2+ on ABETA42 fast aggregation peaked at pH 6.8-7.8, which includes the pH values of the cerebrospinal fluid (pH 7.3) and hippocampus (pH 7.15-7.35). The findings demonstrate the significant effect of Zn2+ on ABETA aggregation and provide new insight into its mechanisms. PMID: 28378589
- These results suggest that APPsw transgenic zebrafish well simulate the pathological characters of Alzheimer's disease and can be used as an economic Alzheimer's disease transgenic model. PMID: 27978793
- The authors found that as already shown for oligomeric Abeta, also oligomeric Tau can bind to amyloid precursor protein (APP). Moreover, efficient intra-neuronal uptake of oligomeric Abeta and oligomeric Tau requires expression of APP. PMID: 28696204
- Recombinant mutant KPI(R13I) domain of ABPP was ineffective in the inhibition of pro-thrombotic proteinases and did not inhibit the clotting of plasma in vitro. PMID: 28499154
顯示更多
收起更多
-
相關疾病:Alzheimer disease 1 (AD1); Cerebral amyloid angiopathy, APP-related (CAA-APP)
-
亞細胞定位:Cell membrane; Single-pass type I membrane protein. Membrane; Single-pass type I membrane protein. Perikaryon. Cell projection, growth cone. Membrane, clathrin-coated pit. Early endosome. Cytoplasmic vesicle.; [C83]: Endoplasmic reticulum. Golgi apparatus. Early endosome.; [C99]: Early endosome.; [Soluble APP-beta]: Secreted.; [Amyloid-beta protein 42]: Cell surface.; [Gamma-secretase C-terminal fragment 59]: Nucleus. Cytoplasm.
-
蛋白家族:APP family
-
組織特異性:Expressed in the brain and in cerebrospinal fluid (at protein level). Expressed in all fetal tissues examined with highest levels in brain, kidney, heart and spleen. Weak expression in liver. In adult brain, highest expression found in the frontal lobe of
-
數據庫鏈接:
Most popular with customers
-
-
YWHAB Recombinant Monoclonal Antibody
Applications: ELISA, WB, IHC, IF, FC
Species Reactivity: Human, Mouse, Rat
-
Phospho-YAP1 (S127) Recombinant Monoclonal Antibody
Applications: ELISA, WB, IHC
Species Reactivity: Human
-
-
-
-
-